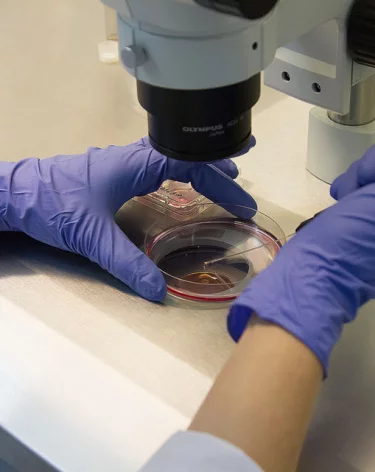
В Новой Москве семья нашла в малосольной рыбе шарики ртути

В Новой Москве семья нашла в малосольной рыбе шарики ртути
В Новой Москве покупатели нашли шарики ртути в упаковке с малосольной рыбой
В Новой Москве супруги обнаружили в упаковке с малосольной рыбой, купленной в одном из магазинов города, шарики ртути. Об этом пишет МК со ссылкой на источники.
По данным издания, супружеская пара купила рыбу в магазине в посёлке Внуково.
Специалисты произвели замеры и выявили небольшое превышение ПДК ртути. Органы Роспотребнадзора проводят проверку.
В результате инцидента никто не пострадал.
Фото: А42.RU